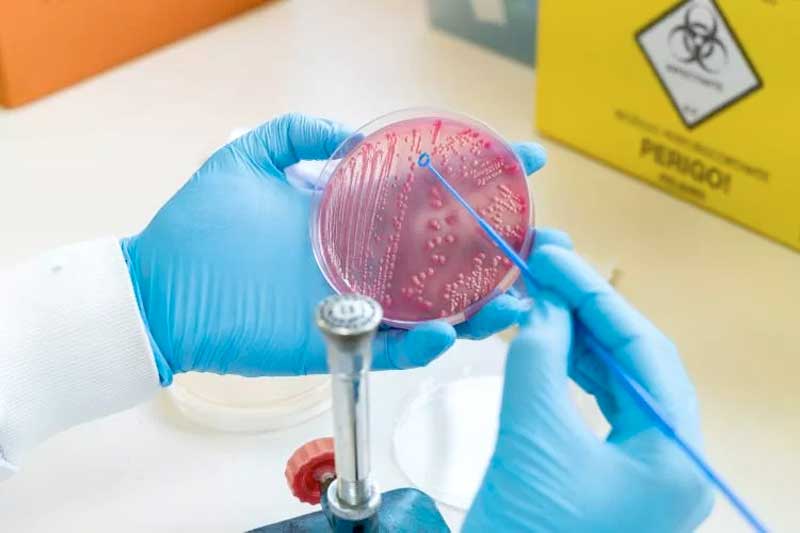

Uma proteína produzida pela bactéria Escherichia coli, denominada Sat, foi identificada por pesquisadores do Instituto Butantan. A estrutura pode ser usada como novo alvo contra infecções, evitando a sepse, que mata no Brasil mais de 300 mil pessoas por ano, de acordo com o Instituto Latino Americano de Sepse (Ilas).
A descoberta foi publicada em 17 de fevereiro na revista Frontiers in Immunology. A sepse acontece como resposta inadequada do organismo a um processo infeccioso, podendo ser causada por vírus, bactérias ou fungos. O problema leva ao mau funcionamento dos órgãos e, portanto, coloca em risco a vida, segundo o Ilas.
A descoberta da proteína da E.coli é especialmente importante no atual contexto de bactérias resistentes a antibióticos. Isso porque a Sat protege a bactéria contra a resposta imune do organismo. Ao buscar compostos que inibam essa proteína, é possível ajudar o sistema imunológico a combater o microrganismo de modo mais eficiente.
O estudo é fruto do doutorado da pesquisadora Claudia Freire, sob coordenação dos pesquisadores do Laboratório de Bacteriologia do Butanan, Waldir Elias e Angela Barbosa. O grupo analisou cepas de E.coli coletadas de pacientes com infecção na corrente sanguínea, obtidas do Hospital São Paulo, em colaboração com Rosa Maria Silva, pesquisadora da Universidade Federal de São Paulo (Unifesp).
“Para terem sucesso causando infecção na corrente circulatória, as bactérias dispõem de vários fatores de virulência, ou seja, mecanismos que as ajudam a driblar o sistema imune do hospedeiro”, explica Waldir, em comunicado. “Descobrimos que a proteína Sat é um desses fatores, já que estava presente em alta frequência nas cepas analisadas”.
Os pesquisadores compararam animais infectados com a bactéria selvagem ou com uma bactéria modificada geneticamente, que não produzia a Sat. Enquanto o grupo infectado pela E.coli selvagem morreu em 48 horas, o segundo grupo apresentou uma redução de 50% da letalidade. Mesmo as cobaias que morreram eventualmente sobreviveram por mais tempo do que as do primeiro grupo.
Freire lembra que Sat é uma protease, isto é, uma enzima que quebra proteínas, após ser secretada pela bactéria na corrente sanguínea. O microrganismo destrói as proteínas do sistema complemento, ou seja, o conjunto de proteínas do sistema imune que respondem rapidamente a uma infecção.
Conforme a infecção piora, a resposta imune se intensifica e pode sair do controle, causando danos ao próprio organismo. Essa dinâmica, que caracteriza a sepse, é uma das principais causas de morte nos hospitais brasileiros. No mundo, a condição mata mais de 6 milhões de pessoas, de acordo com a Organização Mundial da Saúde (OMS).
Conhecer os danos da E. coli pode ajudar os pesquisadores a criarem tratamentos para o início de infecções, evitando que o quadro evolua para sepse. O próximo passo da equipe é identificar os compostos que inibam a produção da Sat. “Além de prevenir a sepse, esses fármacos alternativos poderiam reduzir a necessidade de antibióticos e ajudar a combater a resistência bacteriana, que é outro grande problema de saúde pública”, destaca Waldir.
Fonte: Site Galileu
















